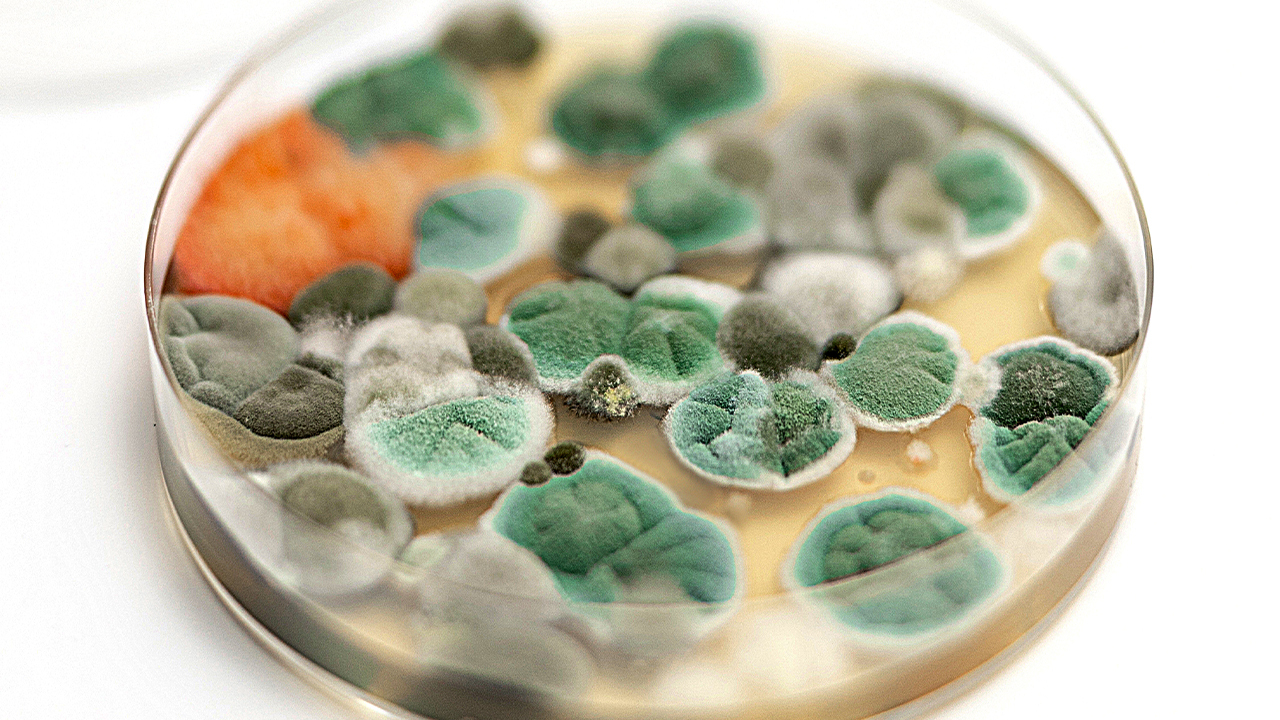

Les moisissures dans la maison peuvent vous rendre malade
D'où viennent les moisissures et que pouvez-vous faire ? L'humidité et les moisissures dans les bâtiments peuvent entraîner des problèmes de santé tels que des problèmes respiratoires et des allergies. Les moisissures se développent dans les environnements humides et se propagent par le biais de spores. Les bâtiments anciens mal isolés ou mal ventilés sont particulièrement exposés aux problèmes d'humidité. Vous pouvez prévenir les moisissures en vous attaquant rapidement aux problèmes d'humidité et aux dégâts des eaux. Maintenez l'humidité intérieure en dessous de 70 % et assurez une bonne ventilation. Soyez attentifs aux signes tels qu'une odeur de moisi et une croissance visible de moisissures.
Qu'est-ce que la moisissure ?
Les spores de moisissures sont présentes partout. Les moisissures se développent en colonies et libèrent des mycotoxines qui les protègent de leurs ennemis. Ces mycotoxines sont présentes dans la poussière des sols, sur le bois et les matériaux à base de cellulose, ainsi que sur les plaques de plâtre humides.
Les moisissures se propagent en libérant des millions de spores dans l'air, ce qui signifie que les spores sont présentes dans tous les bâtiments. Lorsque les conditions propices à la croissance sont réunies, les spores se déposent sur les surfaces humides, commencent à germer et forment un nouveau mycélium. De petits fragments de mycélium peuvent également être transportés dans l'air, ce qui permet à de nouvelles colonies de s'établir.
La taille de la plupart des spores de moisissures varie entre 2 et 10 µm (0,002-0,010 mm), ce qui signifie qu'elles sont facilement transportées par les courants d'air et peuvent pénétrer dans le système respiratoire humain.
Les moisissures se développent principalement sur des matériaux organiques humides tels que le papier peint, le bois et les plaques de plâtre. Les moisissures ne se développent dans les bâtiments que lorsque les matériaux sont suffisamment humides, avec un taux d'humidité équivalent à l'équilibre avec l'air à une humidité relative de 75-80%. En d'autres termes, lorsque l'humidité relative est inférieure à 70 %, il est peu probable que des moisissures se développent. Cependant, des conditions d'humidité localisées, telles que la pénétration de l'humidité dans les murs, peuvent toujours se produire.
Les moisissures jouent un rôle important dans les cycles nutritifs de la nature et sont également utilisées dans les industries alimentaires et pharmaceutiques. Cependant, les moisissures peuvent également provoquer une gêne et des effets néfastes sur la santé, tant à l'intérieur qu'à l'extérieur.
Comment les moisissures affectent-elles la santé humaine ?
Les moisissures produisent des allergènes (substances pouvant provoquer des réactions allergiques) et des irritants. L'inhalation ou le contact avec des moisissures ou des spores de moisissures peut déclencher des réactions allergiques chez les personnes sensibles.
Les réactions allergiques aux moisissures sont courantes et peuvent être immédiates ou retardées. Les moisissures peuvent également déclencher des crises chez les asthmatiques qui y sont allergiques.
L'irritation
L'irritation est l'effet sanitaire le plus fréquent associé à l'exposition à l'humidité et à la formation de moisissures. Les symptômes peuvent inclure une irritation des yeux, du nez et des voies respiratoires supérieures, des maux de tête, de la fatigue, de la toux et des éruptions cutanées. Les personnes souffrant de rhume des foins et d'asthme sont particulièrement sensibles. De plus, l'irritation des voies respiratoires peut augmenter le risque d'infections respiratoires.
Les enfants qui grandissent dans des maisons à forte humidité ont un risque accru de développer de l'asthme. Dans des cas extrêmes, lorsque les moisissures se développent de manière importante et que l'air contient une forte concentration de mycotoxines, des réactions toxiques graves ont été observées.

Allergies
Des réactions allergiques peuvent se produire en cas d'exposition répétée à des moisissures contenant des protéines antigéniques (allergènes). Il est rare que des personnes développent des allergies aux moisissures uniquement parce qu'elles vivent dans des bâtiments humides, mais le risque est plus élevé pour les personnes déjà prédisposées à des allergies telles que le rhume des foins ou l'asthme, ou pour celles qui ont des voies respiratoires sensibles. Les personnes déjà allergiques aux moisissures peuvent voir leurs symptômes s'aggraver.
Les recherches sur le lien entre les moisissures et les effets sur la santé se poursuivent.

L'importance de réguler le climat intérieur
Un environnement intérieur humide peut favoriser le développement de moisissures et d'acariens. Comme les Occidentaux passent 80 à 90 % de leur temps à l'intérieur, un bon climat intérieur est essentiel pour la santé et le bien-être, en particulier en ce qui concerne l'humidité, les moisissures et la santé.
Les dégâts dus à l'humidité et les problèmes de moisissure surviennent souvent dans les bâtiments anciens mal isolés et mal ventilés.
L'humidité relative (HR) désigne la pression de vapeur d'eau existante dans l'air, exprimée en pourcentage de la pression de vapeur saturée à la même température. L'humidité relative reflète à la fois la quantité de vapeur d'eau dans l'air et la température de l'air. Par exemple, l'humidité relative augmentera si la température d'une masse d'air diminue mais qu'aucune eau n'est éliminée. Si l'air se refroidit suffisamment, une partie de la vapeur d'eau se condense en eau liquide. La température la plus élevée à laquelle la condensation se produit est appelée "point de rosée".
Quels sont les signes de la présence de moisissures dans un bâtiment ?
Si vous pensez que des symptômes de santé, tels que ceux mentionnés ci-dessus, sont causés par un bâtiment humide où se développent des moisissures, vous devez faire appel à des professionnels pour évaluer la propriété.
Un problème d'humidité prolongé pendant plusieurs semaines ou plus entraîne généralement la formation de moisissures et la libération de spores dans l'air intérieur, ce qui augmente le risque d'exposition. Les problèmes d'humidité de courte durée qui s'assèchent en quelques jours ne risquent pas d'entraîner la formation de moisissures.
Attention aux taches noires
Les moisissures apparaissent souvent sous forme de taches noires, mais elles peuvent être difficiles à détecter parce qu'elles se développent derrière le papier peint ou dans les cavités murales. La moisissure peut également se développer dans des systèmes de ventilation mal isolés ou dans des unités de climatisation dont les tuyaux d'évacuation sont bouchés.
Les meubles placés contre des murs extérieurs peu isolés, ainsi que les murs autour des salles de bains, sont des endroits propices à la formation de moisissures. L'air provenant des vides sanitaires pénètre souvent dans le bâtiment et peut contenir des spores de moisissures, des fragments et une odeur de moisi.
Une odeur de moisi ?
Une forte odeur de moisi est un bon indicateur de problèmes d'humidité. Cette odeur est causée par les moisissures qui émettent des composés organiques volatils (COV), lesquels peuvent créer une odeur de moisi ou d'humidité. Cependant, les COV dans les concentrations trouvées dans les environnements intérieurs ne sont pas considérés comme causant directement des maladies. Certaines bactéries, en particulier celles du genre Streptomyces, qui sont également associées aux bâtiments humides, peuvent produire de fortes odeurs de moisi.

Pourquoi y a-t-il de l'humidité dans les maisons ?
Les problèmes d'humidité dans les habitations ont de nombreuses causes :
- L'humidité ascendante. L'eau du sol s'infiltre dans le bâtiment. Ce phénomène est fréquent dans les bâtiments anciens et peut également être causé par des défauts de construction dans les bâtiments plus récents. Parmi les facteurs qui y contribuent, citons les canalisations bouchées, l'étanchéité insuffisante des fondations et l'évacuation insuffisante ou obstruée des eaux de toiture.
- Une forte humidité intérieure due à des activités telles que le bain, la cuisine, le nettoyage, la lessive et la respiration humaine et animale. Si la quantité d'humidité ajoutée à l'air intérieur est supérieure à celle évacuée par la ventilation, l'humidité peut se condenser sur les surfaces, telles que les fenêtres.
- Ventilation insuffisante, qu'elle soit naturelle ou mécanique.
- Mauvaise isolation, créant des ponts thermiques.
- Les infiltrations d'eau dues aux inondations ou à la pluie.
- Dommages causés par l'eau dans les structures des bâtiments en raison d'un séchage inadéquat des matériaux de construction ou de défauts de construction, ce qui peut également se produire dans les propriétés nouvellement construites.
- Fuites de canalisations, visibles ou cachées, dues à la corrosion, à des ruptures ou à des joints non étanches. Outre les inondations majeures, les petites fuites non détectées sont les plus dommageables, car elles peuvent créer des problèmes d'humidité au fil du temps, favoriser la formation de moisissures et endommager les matériaux et les structures des bâtiments.

Comment prévenir les moisissures dans votre maison ?
Pour minimiser les risques pour la santé, il est essentiel d'identifier et de traiter rapidement la cause de l'humidité, d'éliminer efficacement les moisissures et d'assurer un séchage rapide des zones touchées afin d'éviter qu'elles ne se reproduisent. Dans certains cas, vous pouvez vous en charger vous-même, mais l'aide d'un professionnel est souvent nécessaire pour que le travail soit bien fait. Tout dégât des eaux doit être réparé, car il provoque non seulement la formation de moisissures, mais il peut également affaiblir la structure du bâtiment et ses propriétés d'isolation.
Les professionnels du bâtiment peuvent procéder à une inspection technique d'un bien immobilier, en se concentrant sur la formation de moisissures. Des échantillons peuvent être prélevés sur les murs, le papier peint, les boiseries et d'autres matériaux afin d'identifier la formation de moisissures dans les zones endommagées par l'humidité.
Réduire le taux d'humidité
Il est essentiel de réduire l'humidité, soit en augmentant la ventilation, soit en déshumidifiant. Le chauffage seul n'est pas une solution suffisante. L'air chaud peut contenir plus d'humidité que l'air froid, ce qui entraîne une baisse de l'humidité relative. Cependant, lorsque l'air chaud entre en contact avec des surfaces froides, l'humidité peut se condenser sous forme d'humidité. Ce phénomène se produit souvent autour des fenêtres, dans les zones mal isolées (ponts thermiques) ou dans les pièces mal chauffées. Le maintien d'une température basse dans les chambres à coucher peut favoriser la formation de moisissures dans ces espaces ; les chambres doivent donc être bien ventilées et chauffées pendant la journée.
Si un mur humide reste chaud en raison de la lumière du soleil ou de la proximité d'une chaufferie, la moisissure peut se développer rapidement, car des températures plus élevées favorisent la croissance.
Idéalement, l'humidité intérieure devrait être maintenue en dessous de 70 % et de préférence à 45-50 %. Cet objectif peut être atteint grâce à des températures stables, à la ventilation et, si nécessaire, à la déshumidification.
Divers humidimètres peuvent mesurer l'humidité relative et les niveaux d'humidité des matériaux.
Vous souhaitez plus d'informations sur la manière dont Dantherm Group peut aider les professionnels à gérer les projets de moisissure ? Contactez-nous dès maintenant !
Sources :
- Moisissures et santé. Agence américaine pour la protection de l'environnement (https://www.epa.gov/mold/mold-and-health).
- Espaces intérieurs humides et santé. Comité de l'Institute of Medicine sur les espaces intérieurs humides et la santé. Washington (DC) : National Academies Press (US), 2004. (https://www.ncbi.nlm.nih.gov/books/NBK215649/).
- "Health Issues Related to Damp and Mould in Buildings - On Assessment and Diagnosis in General Practice" (Titre original : Helbredsproblemer ved fugt og skimmelsvampe i bygninger - Om udredning og diagnostik hos alment praktiserende læger). Autorité sanitaire danoise 2006 (https://www.sst.dk/da/udgivelser/2006/Helbredsproblemer-ved-fugt-og-skimmelsvampe-i-bygninger---om-udredning-og-diagnostik-hos-alment-prak)
- www.skimmel.dk - Centre de connaissances danois indépendant géré par le Fonds national de la construction, le Fonds d'investissement des propriétaires fonciers et BUILD (anciennement l'Institut danois de recherche sur la construction).
Produits associés
Articles vedettes
Depuis son installation au début de l'année 2023, le déshumidificateur a éliminé un minimum de 10 litres d'eau par jour.
Économisez du temps et de l’argent en éliminant l’humidité sous les sols
Découvrez tout ce que vous devez savoir pour entamer un projet de restauration suite à un dégâts des eaux.
Besoin d'aide pour choisir la bonne solution ? Notre équipe de plus de 100 experts en solution pour le climat peut vous aider.
Vous pouvez également contacter ou rejoindre la discussion sur nos réseaux sociaux. Consultez notre page LinkedIn.